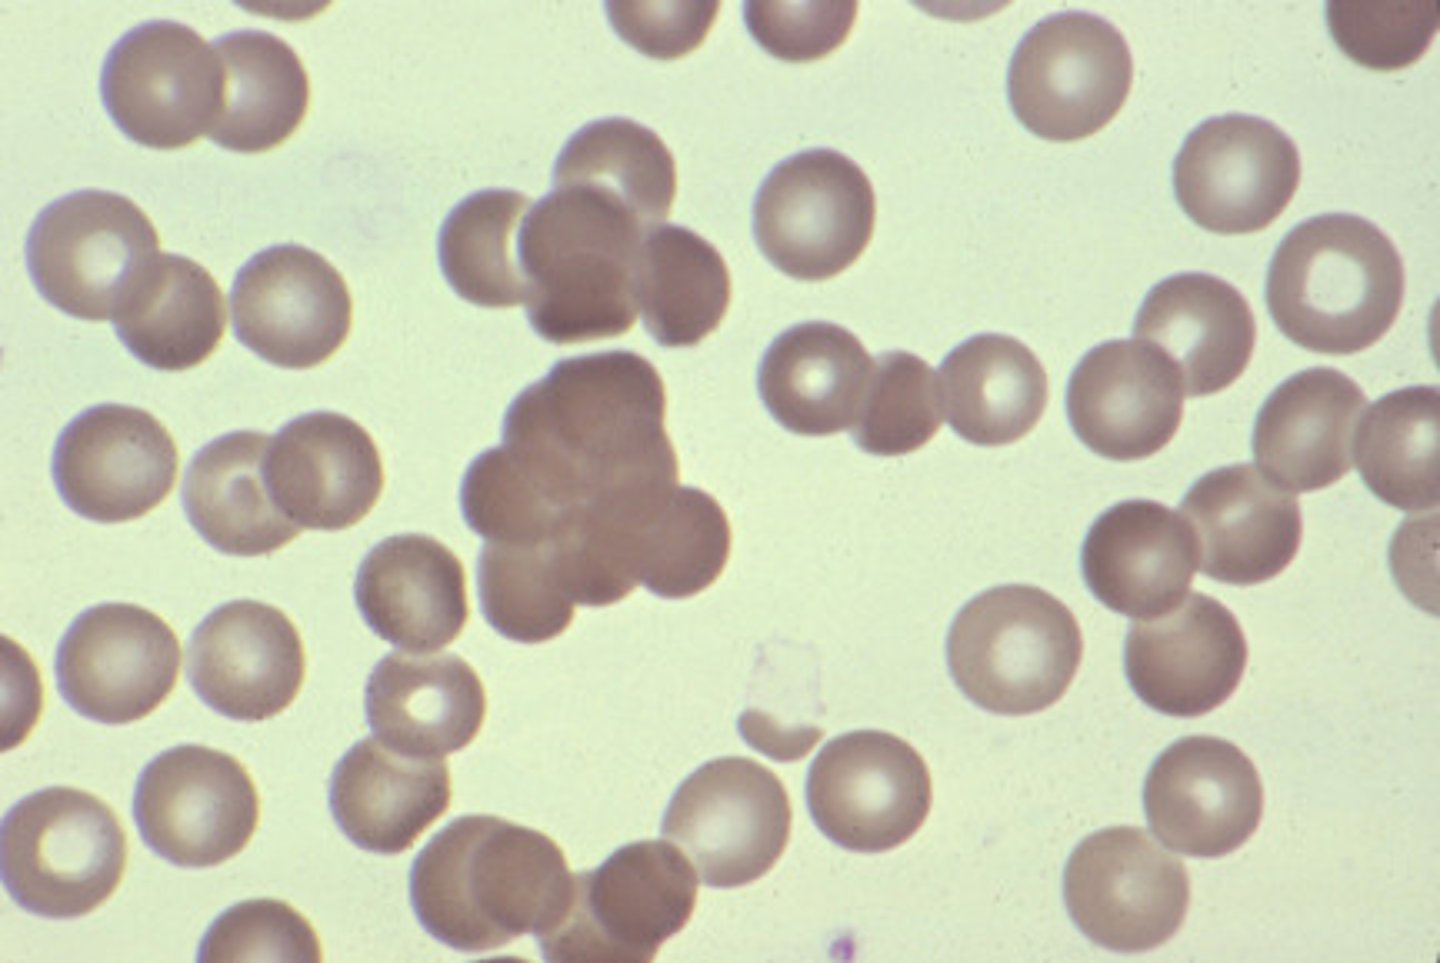
<p>clumping of RBC's</p>
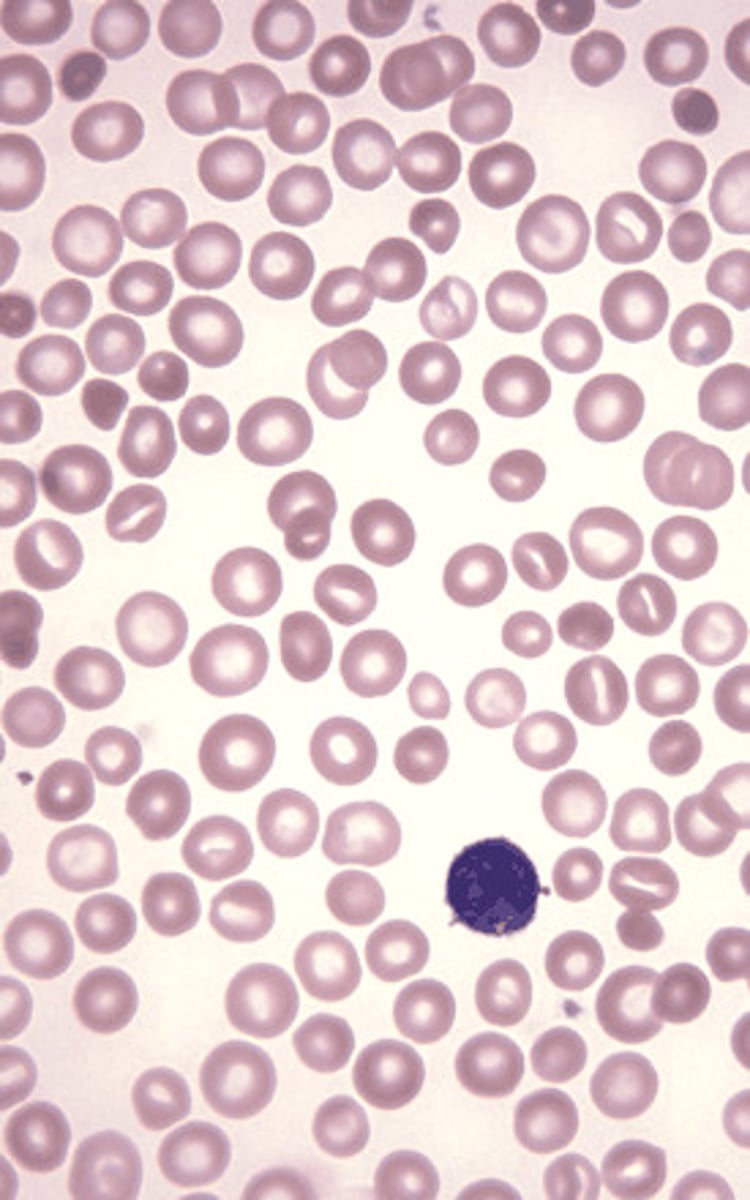
<p>presence of red blood cells of unequal size</p>
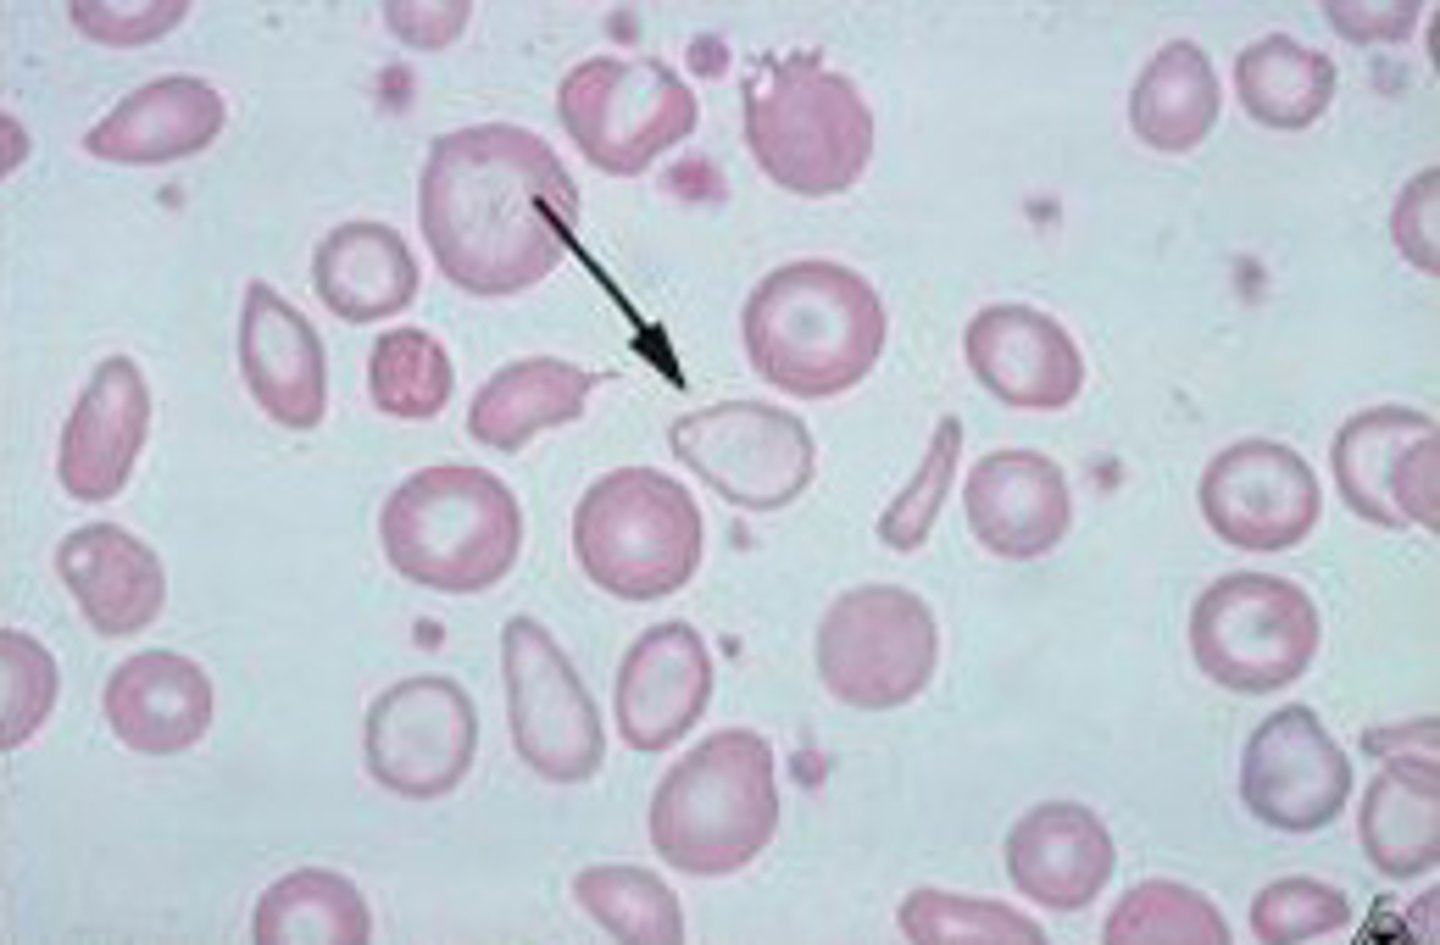
<p>little or no color in cell due to inuffeicient Hb with in the cell. Low Iron.</p>
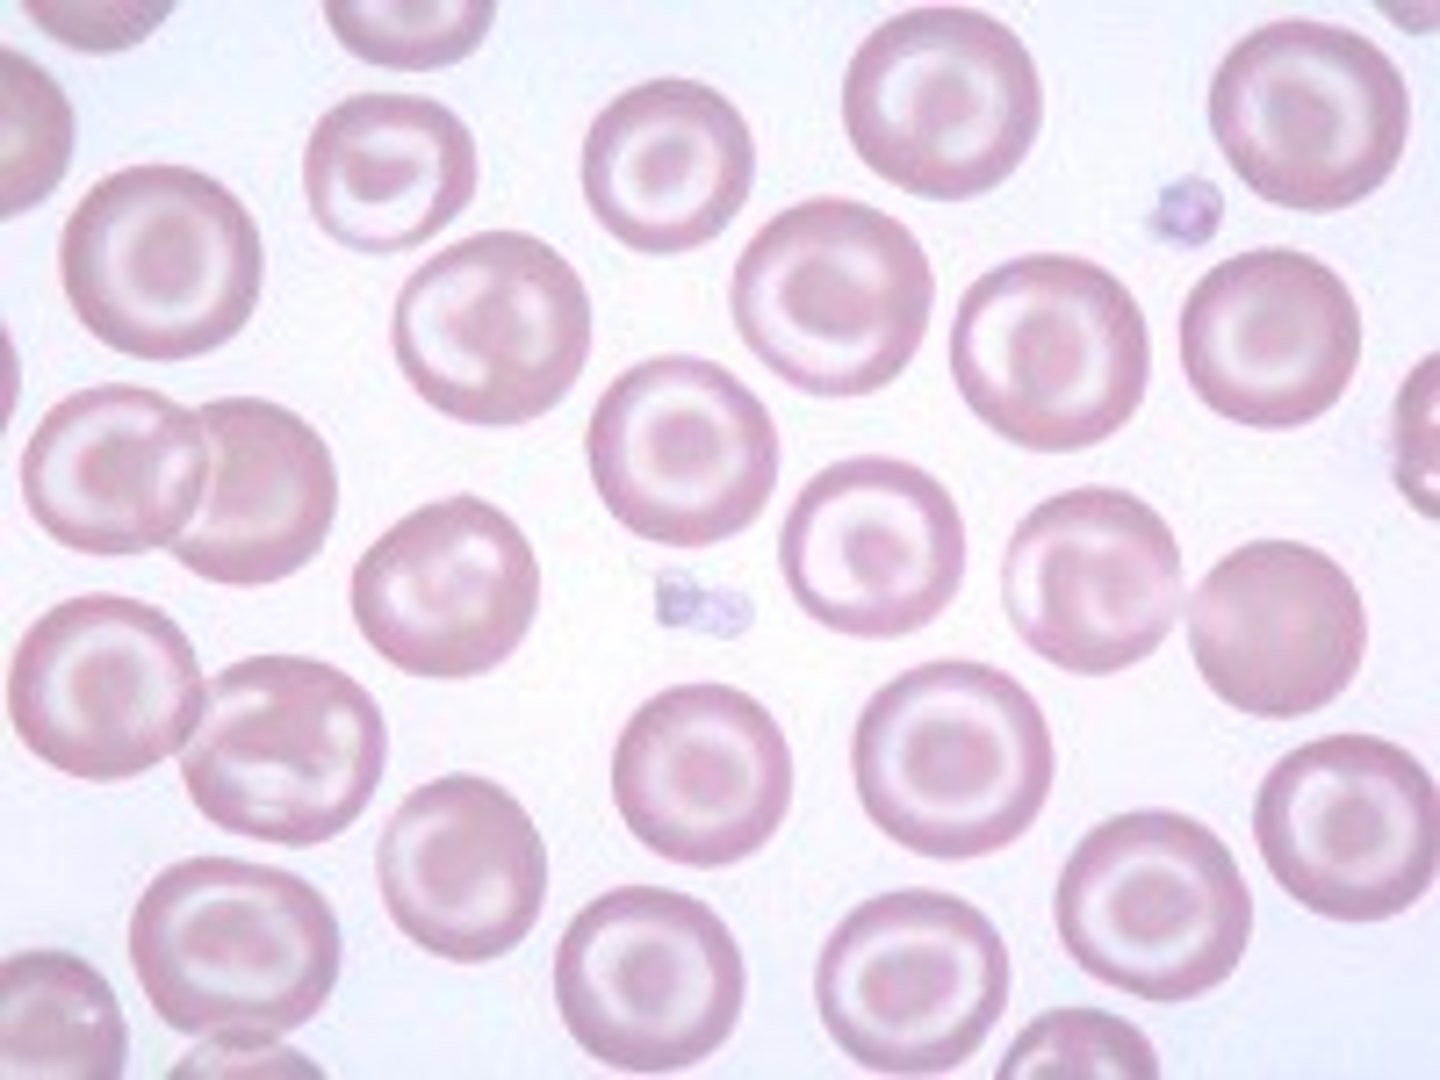
<p>Cells with less volume and are 'flattened out.' Folded cell has transverse fold. Target cell looks like a target. Both are associated with chronic anemia, liver disease,dyserythropoiesis</p>
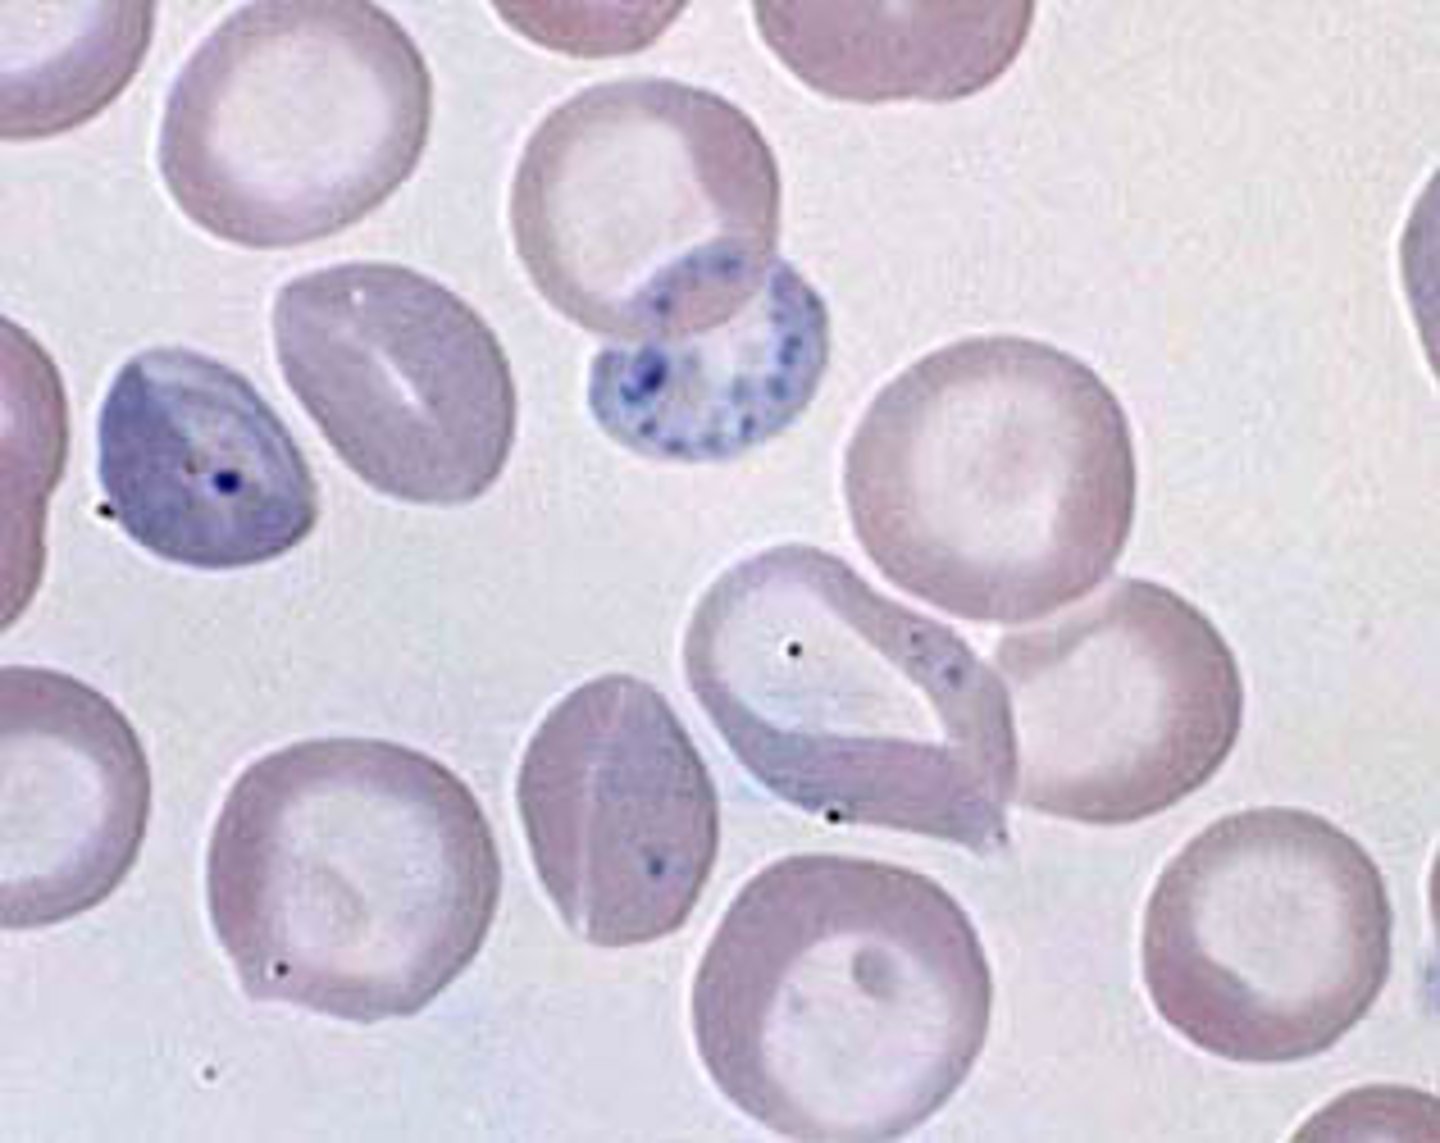
<p>deep blue stippling due to ribosomes. regenerative anemia, lead poisoning.</p>
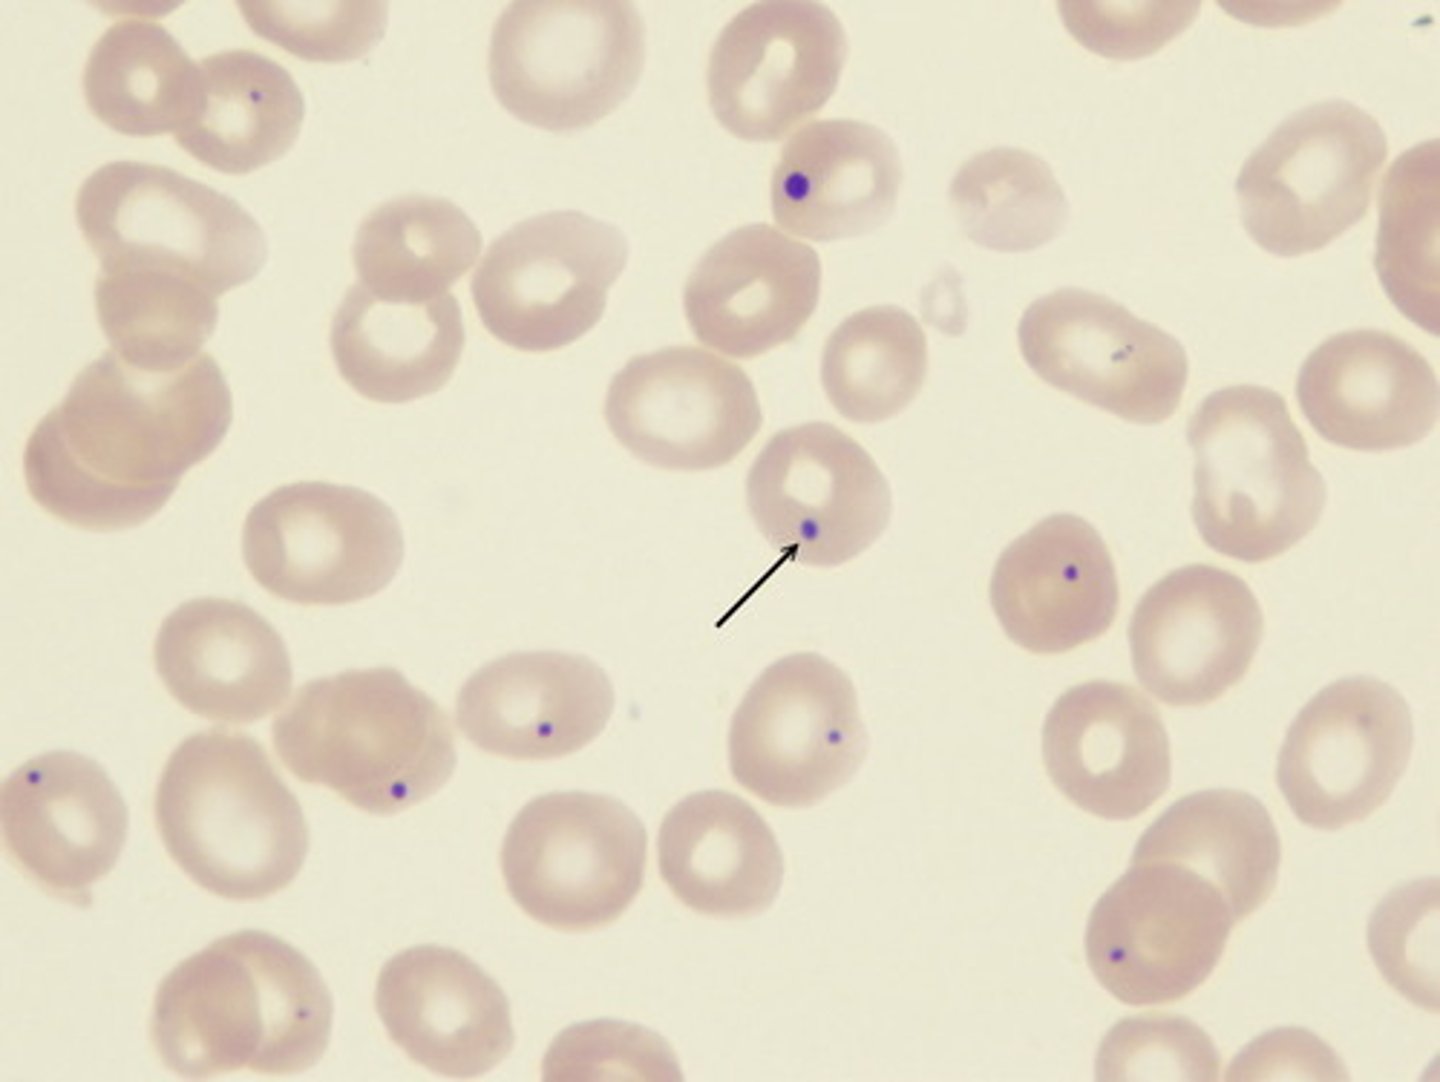
<p>remnants of chromatin, severe anemias or aspleenia</p>
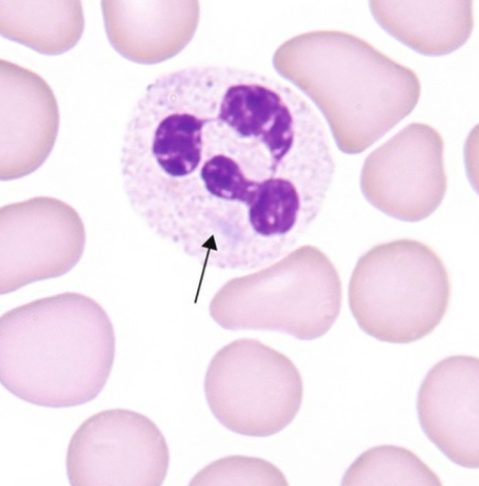
<p>Pale blue, round/oval/rod shaped RNA inclusions, found in neutrophils and eosinophils, often seen with toxic granulation and May-Hegglin, and seen in bacterial infection, burns, cancer</p>
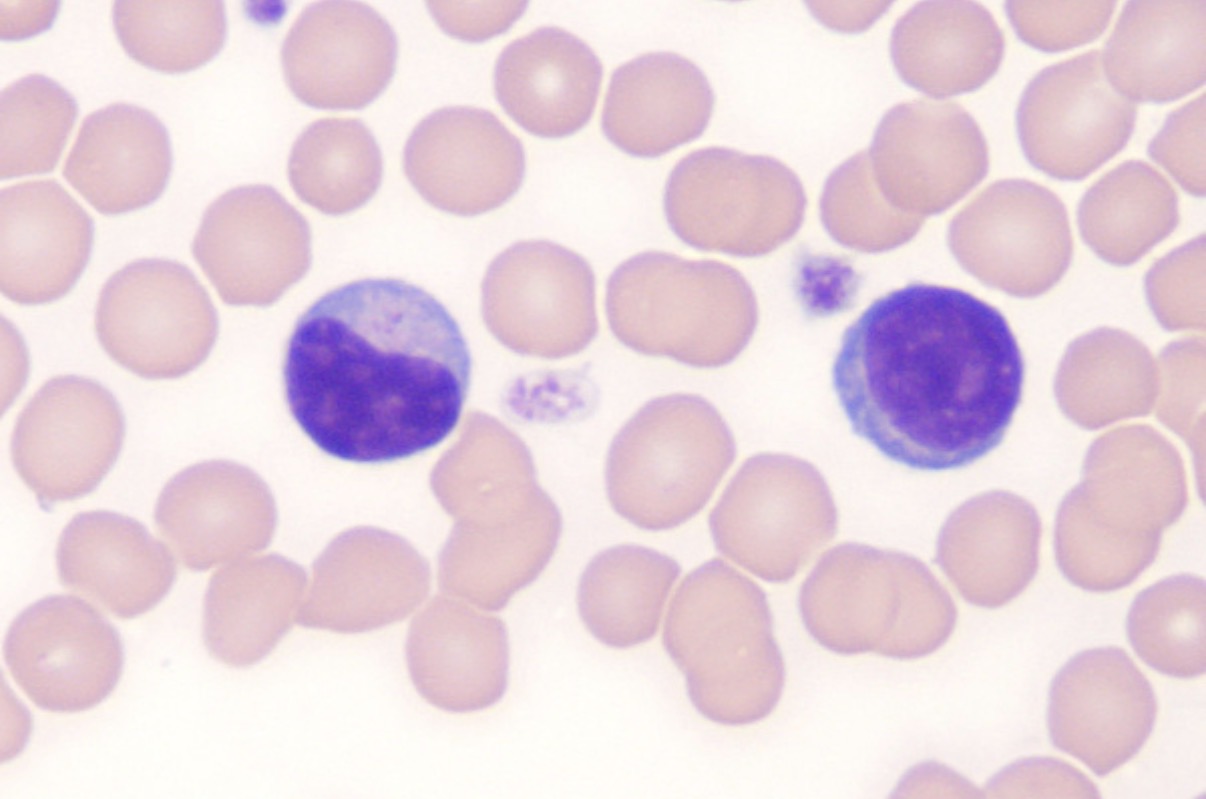
<p>Atypical lymphocytes with abundant cytoplasm and irregular nuclei, indicating a response to viral infections or other stimuli, commonly observed in infection or inflammatory conditions, increase in cytoplasmic basophilia, more likely to occur in b-lymphocytes and plasma cells</p>
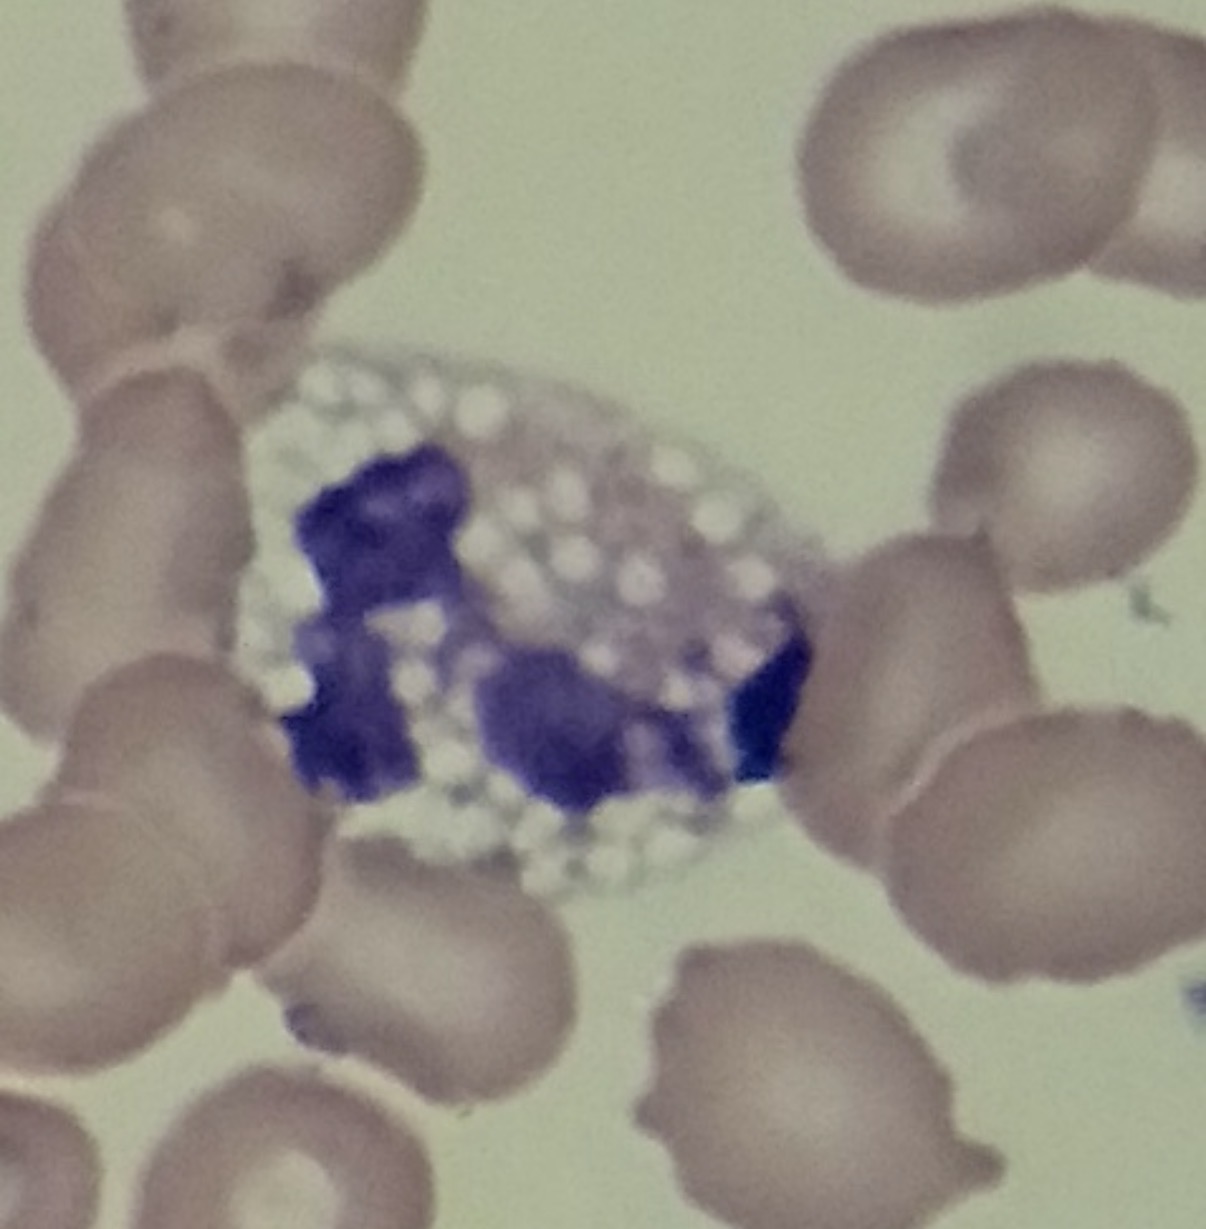
<p>Membrane bound sacks of fluid, <span>cellular stress, injury, or nutrient deprivation, swollen organelles like the endoplasmic reticulum or Golgi apparatus. It is commonly driven by metabolic disruption, infections, toxins, or senescence</span></p>
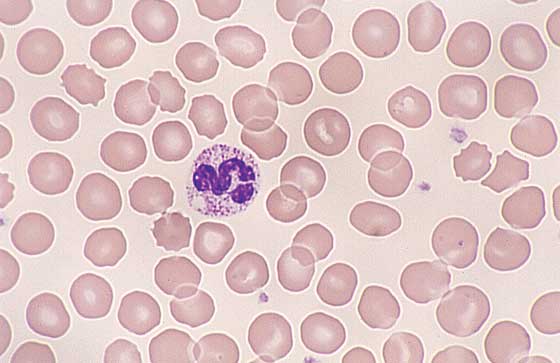
<p>Increase in cytoplasmic basophilia, bigger, toxic granulation, <mark data-color="rgba(0, 0, 0, 0)" style="background-color: rgba(0, 0, 0, 0); color: inherit;">prolonged cell life</mark><span>, often linked to severe chronic inflammation or infection,</span></p>

RBC Morphology/ WBC Morphology
1/25
There's no tags or description
Looks like no tags are added yet.
Name | Mastery | Learn | Test | Matching | Spaced | Call with Kai |
|---|
No analytics yet
Send a link to your students to track their progress
26 Terms
Rouleaux
a clump of red blood cells that appear to be stacked like a roll of coins

agglutination
clumping of RBC's
polychromasia
Term for a pale-blue RBC in routine stains, due to RNA content

anisocytosis
presence of red blood cells of unequal size
hypochromasia
little or no color in cell due to inuffeicient Hb with in the cell. Low Iron.
poikilocytosis
Cells are irregularly shaped

echinocytes
evenly spaced crenation, non-specific disease, rattlesnake envenomation, blood transfusion

acanthocytes
spur cells. resemble creanated cells. have multiple irregularly spaced rounded or clublike projections over entire surface of cell. result from alterations in cell membrane, often seen with kidney or liver disease, hemangiosarcoma, DIC, GN

stomatocytes
uniconcave erythrocytes with mouth like clear area near cell center; a few in a blood smear are insignificant; hereditary in some breeds (alaskan malamutes, schnauzers)

schistocytes
Fractured or fragmented RBC. microangiopathy, DIC, iron deficiency, liver disease, heart failure, GN, hemangiosarcoma

keratocytes
intact or ruptured vesicles on edge of RBC, seen in iron deficiency anemia, liver disease

spherocytes
Sphere spaed, lack central pallor. IMHA, zinc toxicity, blood parasites, bee sting, snake envenomation, transfsion

leptocytes, target cells, codocytes
Cells with less volume and are 'flattened out.' Folded cell has transverse fold. Target cell looks like a target. Both are associated with chronic anemia, liver disease,dyserythropoiesis
eccentrocytes
Shifting of Hb to one side of the cell, resulting in a clear zone outlined by membrane; oxidant injury: onions, tylenol, vitamin K

Heinz bodies
"nose" of Denatured Hemoglobin, stains well with New Methylene Blue stain, Can be seen in cats, Can lead to anemia. diabetes, hyperthyroidism, lymphoma, or normal

ovalocytes
oval shaped, hereditary in dogs, myelofibrosis, MDS, cats with bone marrow disease, hepatic lipidosis

dacrocytes
tear drop shaped. results from failure of the cell to resume its normal shape after passage thru capillaries. Or, can also be an artifact of smear preparation. Tails same direction= artifact of staining. tails opposite direction= myelofibrosis.

basophilic stippling
deep blue stippling due to ribosomes. regenerative anemia, lead poisoning.
siderocytes
clustered blue dots of iron; lead poising,

Howell-Jolly
remnants of chromatin, severe anemias or aspleenia
Smudge Cells
Smudged nucleus with no cell membrane or granules, produced by blood smear preparation, and common in Chronic Lymphocytic Leukemia due to cell fragility

Dohle Bodies
Pale blue, round/oval/rod shaped RNA inclusions, found in neutrophils and eosinophils, often seen with toxic granulation and May-Hegglin, and seen in bacterial infection, burns, cancer
Reactive Lympocytes
Atypical lymphocytes with abundant cytoplasm and irregular nuclei, indicating a response to viral infections or other stimuli, commonly observed in infection or inflammatory conditions, increase in cytoplasmic basophilia, more likely to occur in b-lymphocytes and plasma cells
Vaculation
Membrane bound sacks of fluid, cellular stress, injury, or nutrient deprivation, swollen organelles like the endoplasmic reticulum or Golgi apparatus. It is commonly driven by metabolic disruption, infections, toxins, or senescence
Neutrophil Gigantism
Increase in cytoplasmic basophilia, bigger, toxic granulation, prolonged cell life, often linked to severe chronic inflammation or infection,
Pelge-Huet
A benign, inherited genetic condition causing white blood cells (neutrophils) to have hyposegmented nuclei, homozygous (pups die in utero or are stillborn due to severe skeletal abnormalities), common in australian shepherds